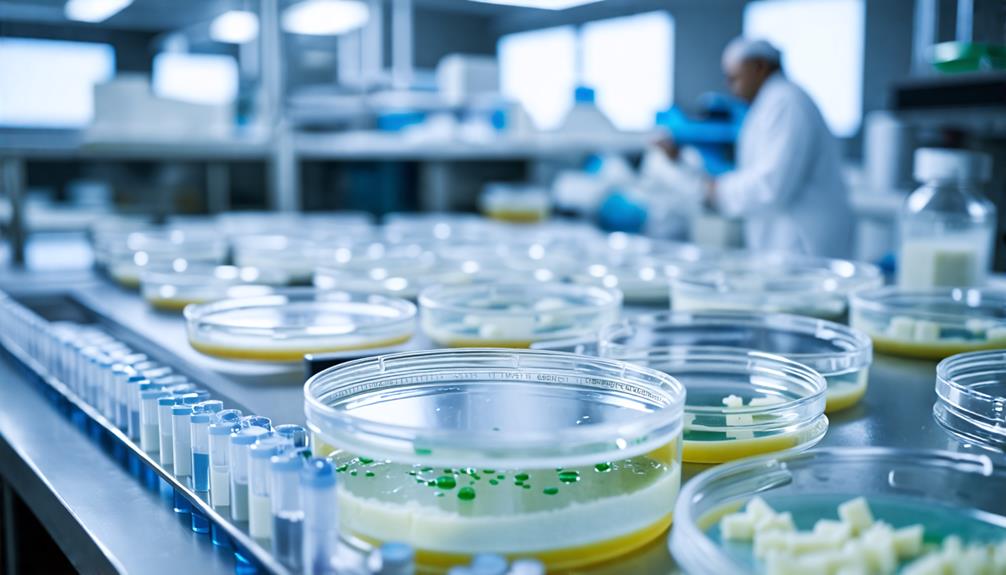

Can Cheese Be Made From Human Bacteria, and What Is Bio-Cheese?
Have you ever considered the possibility of making cheese using human bacteria? This concept, known as bio-cheese, employs bacterial cultures derived from our own microbiomes to create unique flavors and potentially personalized nutrition. While it might sound unconventional, the science of fermentation makes this innovation possible. However, significant safety and ethical considerations must be addressed. What could this mean for the future of food? Let's explore these complexities together.
Understanding Bio-Cheese

Bio-cheese is an innovative concept that uses human-derived bacterial cultures to create unique flavors and nutritional profiles in cheese. This method differs from traditional cheese-making, which typically utilizes animal-derived bacteria. With bio-cheese, there is the potential to develop cheeses that reflect individual microbiomes, making each cheese a personal signature.
In this process, specific strains of bacteria are isolated from human microbiomes, influencing the fermentation, flavor, and texture of the cheese. Imagine tasting a cheese that not only pleases your palate but also aligns with your body's unique bacterial composition.
However, the journey into bio-cheese production is just beginning. Researchers face challenges, including safety concerns and regulatory hurdles associated with using human-derived cultures in food. While it's exciting to consider the new varieties of cheese that could emerge, it's crucial to ensure these innovations maintain food safety and quality. Understanding bio-cheese involves balancing creativity in cheese-making with the rigorous standards needed to bring these unique products to your table.
The Science of Fermentation
Understanding fermentation is key to appreciating the unique flavors and textures in cheese production. Fermentation is a metabolic process where microorganisms like bacteria, yeast, or molds convert sugars into acids, gases, or alcohol. This transformation is vital for food preservation and flavor development, particularly in cheese.
In cheese-making, specific bacterial cultures are introduced to the milk, significantly impacting the final product's character. Traditional methods rely on naturally occurring bacteria, while modern techniques often use selected starter cultures for consistent results. These fermentation processes produce byproducts like lactic acid, which preserve the cheese and enhance its flavor.
The complex microbial interactions among different bacterial strains create a diverse array of flavors and textures. By studying these interactions, cheesemakers can innovate and develop unique cheese varieties that expand traditional flavors. Ongoing research in food science is crucial for understanding how to harness these fermentation processes for better flavor development, enriching our cheese experience. Whether you're a cheese aficionado or a curious foodie, understanding the science behind fermentation deepens your appreciation for this beloved dairy product.
Human Bacteria in Cheese

Harnessing human bacteria in cheese-making offers a novel approach to fermentation, potentially resulting in unique flavors and textures. The human microbiome contains diverse bacterial strains that could be used for bacterial culture sourcing, complementing traditional methods. By utilizing these unique bacterial cultures, it's possible to create bio-cheese with characteristics not found in conventional cheeses.
Research into human-derived bacteria could facilitate fermentation advancements, enabling cheese-makers to explore flavor profiles that challenge the norm. Each human microbiome contributes different flavors, potentially transforming the cheese-making landscape. However, the current understanding of how specific human bacteria influence taste and texture remains limited.
Considering the potential of using human bacteria in cheese production requires an open mind. This approach encourages both culinary creativity and scientific inquiry, but it also raises questions about safety and public perception. While the concept is intriguing, further studies are necessary to develop guidelines and best practices for bio-cheese production, balancing innovation with consumer trust.
Flavor Profiles and Safety
Exploring the flavor profiles of cheese made with human bacteria opens up a fascinating domain of possibilities, but safety concerns must also be addressed to guarantee consumer confidence. The flavor complexity of such cheeses remains largely uncharted territory. While traditional cheese relies on established bacterial cultures to create unique flavors, the impact of human bacteria is still uncertain. Research is vital to determine how specific human bacterial strains might influence both flavor and safety.
Safety standards are fundamental when considering the incorporation of human bacteria into cheese production. The potential presence of pathogenic strains or harmful microorganisms poses significant risks that can't be overlooked. Understanding microbial interactions during fermentation is critical, as these interactions will dictate the final product's safety and taste.
Public perception will also play a significant role in the acceptance of bio-cheese. Misconceptions about harmful bacteria could hinder consumer trust, despite the benefits that beneficial bacteria can provide. By addressing safety concerns and exploring flavor profiles through rigorous research, the cheese-making industry can cautiously navigate this groundbreaking frontier, ultimately enhancing both the culinary experience and consumer safety.
Ethical Considerations in Bio-Cheese

When considering bio-cheese, it's important to evaluate the health implications of consuming products derived from human bacteria. Additionally, reflect on how cultural acceptance and societal norms influence perspectives on this novel food source. These ethical considerations are crucial as we explore the future of food production.
Health Implications of Bio-Cheese
Bio-cheese, made from human bacteria, raises significant ethical concerns about consent and the use of our biological materials in food production. Given the limited research available, it's essential to be cautious about the potential health implications of consuming this innovative product. While bio-cheese might offer unique nutritional benefits, such as enhanced probiotics, the effects on your microbiome remain largely unknown.
The interaction of these bacteria with your gut health is a critical area of concern, especially since individual microbiomes vary widely. Consumer perceptions significantly influence the acceptance of bio-cheese; many might feel uneasy about consuming a product derived from human bacteria. This discomfort often stems from safety concerns and the unfamiliar nature of such products.
Moreover, the introduction of bio-cheese could challenge existing food safety regulations, sparking debates over necessary updates and guidelines. Before embracing this new food innovation, it is crucial to thoroughly assess its safety and nutritional value, ensuring alignment with your health needs and ethical standards. Staying informed as research progresses will help you make educated choices about whether bio-cheese is right for you.
Cultural Acceptance and Norms
Cultural acceptance of bio-cheese is influenced by deeply ingrained norms and values surrounding food safety and hygiene. Cultural perceptions around food taboos play a significant role in how people view using human bacteria in cheese-making. While some cultures may embrace culinary innovation, others might resist due to fear or misunderstanding.
| Cultural Factors | Impact on Bio-Cheese Acceptance |
|---|---|
| Food Safety Concerns | Increased skepticism about human bacteria |
| Traditional Food Values | Resistance to unconventional food practices |
| Openness to Creativity | Potential for greater acceptance |
Many people associate bacteria solely with pathogens, raising ethical questions about the commodification of human microbiomes. Additionally, using human-derived bacteria in food without explicit consent raises serious ethical concerns. To foster acceptance, it is crucial to educate the public about the benefits of beneficial bacteria in food production. Addressing misconceptions can help bridge the gap between traditional food beliefs and innovative culinary practices, paving the way for bio-cheese to potentially become a globally accepted food product.
Future of Personalized Nutrition
The future of personalized nutrition is set to transform your dietary habits by customizing food choices based on your unique microbiome and metabolic requirements. Emerging research underscores the pivotal role of microbial diversity in shaping metabolic responses, highlighting the inadequacy of a one-size-fits-all diet. Advances in DNA sequencing and metabolic profiling are making dietary customization increasingly attainable, enabling tailored recommendations that align with your specific health objectives.
Envision a scenario where your meals are meticulously crafted to suit you, taking into account how your gut bacteria influence nutrient absorption and even your mood. This paradigm shift in nutrition not only enhances your health but also paves the way for innovative food products, such as bio-cheese made from human-derived bacteria, offering distinct flavors and superior nutritional value.
Ongoing research is exploring the impact of specific bacterial cultures within your microbiome on your dietary habits. This personalized approach has the potential to empower you with the knowledge to optimize your diet and improve your overall well-being. Embracing personalized nutrition could fundamentally alter your relationship with food and health.
Conclusion
Bio-cheese stands at the intriguing crossroads of culinary innovation and personalized nutrition. By utilizing human bacteria, it offers unique flavors tailored to individual preferences and health needs. However, it is essential to consider the safety, ethical, and cultural implications of this novel cheese-making method. As research advances, bio-cheese could revolutionize the cheese experience, making it not just a food choice but a reflection of personal identity and wellness.




